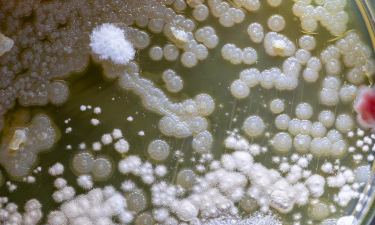
家庭养花用生根粉

养花人推荐花瓶
在养花时,花瓶的选择不仅影响美观,还会影响植物的生长和观赏效果。以下是几种常见的花瓶推荐及使用建议:
1. 陶瓷花瓶
- 优点:传统且经典,质感好,适合多种花种,能很好地保持花的形态。
- 适用场景:适合大多数花卉,尤其是对水质要求较高的植物,如多肉、观叶植物等。
- 使用建议:选择釉质较厚的陶瓷花瓶,可减少水的渗透,避免花根受损。
2. 玻璃花瓶
- 优点:透明度高,能展示花的色彩和形态,适合观赏性强的植物。
- 适用场景:适合观赏性较强的花卉,如郁金香、蝴蝶兰等。
- 使用建议:玻璃花瓶需注意防撞,避免摔落造成破损。
3. 塑料花瓶
- 优点:轻便、成本低,适合临时使用或小空间种植。
- 适用场景:适合室内小型绿植,如多肉、仙人掌等。
- 使用建议:塑料花瓶易滋生细菌,建议定期清洁并保持干燥。
4. 金属花瓶
- 优点:耐用、现代感强,适合搭配简约风格的家居。
- 适用场景:适合喜欢现代设计风格的养花者。
- 使用建议:金属花瓶易生锈,需定期清洁并涂防锈油。
5. 创意花瓶
- 优点:设计独特,能增加养花的趣味性和艺术感。
- 适用场景:适合喜欢个性化装饰的养花者。
- 使用建议:创意花瓶多为装饰性设计,需注意排水孔是否畅通。
其他建议:
- 花瓶大小:根据植物的根系和生长情况选择合适大小,避免过大或过小。
- 排水孔:确保花瓶底部有排水孔,避免积水导致根部腐烂。
- 清洁维护:定期清洁花瓶,避免细菌滋生,尤其在冬季或潮湿环境下。
如果你有特定的植物类型或风格偏好,我可以为你推荐更合适的花瓶类型。
小天爱养花
小天爱养花,说明你对植物养护有着浓厚的兴趣。养花不仅能让生活更有趣,还能带来心灵的放松。下面是一些关于养花的常见问题和建议,希望能帮助你更好地照顾你的植物。浇水频率植物的浇水频率取决于种类、季节和环境。一般来说,春夏生长季需要每天或隔天浇水
· 2025-11-20

电梯房高楼养花
在电梯房高楼养花是一项挑战,但并非不可能。以下是一些实用的建议,帮助你在有限的空间内成功养花:常绿植物:如绿萝、龟背竹、常春藤等,适合室内养护,耐阴性强,不需要太多阳光。多肉植物:如仙人掌、景天科植物等,耐旱、适应力强,适合在小空间中养护。
· 2025-11-20

土壤过酸养花
土壤过酸会影响植物的吸收和生长,尤其对喜中性或碱性土壤的植物来说更为明显。以下是处理土壤过酸的常见方法:石灰(生石灰):适用于酸性土壤,能中和酸性,提高土壤pH值。但需注意用量,避免过量导致土壤板结。石膏(硫酸钙):可改善土壤结构,中和酸性
· 2025-11-20

娶老婆就当养花
娶老婆就当养花,这句话常用来比喻夫妻之间要像养花一样用心经营,相互扶持、共同成长。在农业领域,养花同样需要细心照料、耐心呵护,才能让植物茁壮成长。以下是一些与养花相关的建议和知识,供你参考:浇水:根据植物种类和季节调整浇水频率,避免积水或干
· 2025-11-20

养花水臭厌氧菌
在养花过程中,如果遇到水臭、厌氧菌等问题,通常与水质污染、水质管理不当或植物根系健康有关。以下是针对此类问题的解决方法:水质检测:定期检测水质,尤其是 pH 值、硝酸盐、氨氮等指标,确保水质符合植物生长需求。避免使用污染水源:不要使用被污染
· 2025-11-20
养花怎么垫底最好
在养花时,垫底是指在花盆底部放置一层基质或土壤,以帮助排水、透气和防止根部积水。垫底的选择应根据花卉种类和种植环境来决定。以下是几种常见的垫底方式及推荐:优点:透气性好,保水性适中,适合大多数花卉。适用情况:适合一般花卉,如多肉、绿植、盆栽
· 2025-11-20

丽波养花日常
丽波养花日常可以遵循以下基本原则,以确保植物健康生长:浇水频率:根据植物种类和土壤湿度决定,避免积水或干旱。浇水方法:用喷壶或浇水壶均匀浇灌,避免直接淋在叶片上,以防病害。注意事项:春夏生长季需保持土壤湿润,秋冬则减少浇水频率。光照需求:不
· 2025-11-20

怎样使用红糖养花
红糖在养花中可以作为一种天然的肥料,具有一定的养分补充和土壤改良作用。以下是使用红糖养花的常见方法:方法:将红糖与水按1:10的比例混合,制成红糖水,浇灌花卉。作用:红糖含有丰富的糖分和微量元素,能够促进植物生长,改善土壤结构,增强植物的抗
· 2025-11-20

制作淘米水养花
淘米水是一种天然的植物生长液,富含氮、磷、钾等营养元素,适合用于浇灌花卉,尤其是对养分需求较高的植物。以下是制作淘米水的步骤:1. 淘米并过滤将米粒洗净,淘净杂质。将淘好的米倒入容器中,加入适量清水,搅拌均匀。用滤网或纱布过滤掉米渣,保留清
· 2025-11-20

盘串养花钓鱼
盘串养花钓鱼是一种结合了园艺与垂钓技巧的活动,通常在水边或池塘边进行,利用盘串(如木盘、竹盘)作为养花的容器,同时也可以作为垂钓的工具。以下是关于盘串养花钓鱼的相关知识和建议:盘串可以用于:养花:作为花盆使用,种植多肉、绿植等植物,使其在水
· 2025-11-20





